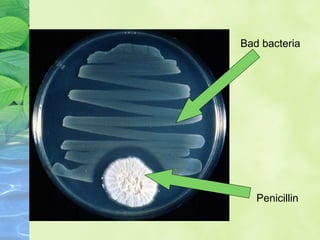
Bad bacteria
Penicillin

Embed presentation
Downloaded 51 times














1) The document is a presentation by Divyanshi Kherajani of class VIII-C about useful microorganisms. 2) It discusses the roles of decomposers like bacteria and fungi in breaking down dead organisms and recycling nutrients, as well as examples of helpful and harmful microbes. 3) Examples of helpful microbes include bacteria and yeasts that are used to make food products like cheese and bread, and fungi like penicillin that are used as medicines to kill harmful bacteria.